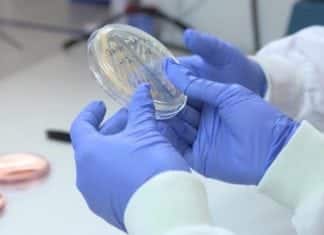
Scientists Unveil The World’s First Non-Leaching Antimicrobial Medical Gloves Scientists Unveil The World’s First Non-Leaching Antimicrobial Medical Gloves

MSc & MTech Biological Sciences Project Associate Post @ IIT Delhi
MSc & MTech Biological Sciences Project Associate Post @ IIT Delhi
MSc and MTech Biological Sciences candidates are invited to work in research positions at...
A Synthetic Mineralised Material that Mimics Hard Tissue Regeneration
A Synthetic Mineralised Material that Mimics Hard Tissue Regeneration
Nature is abundant with examples of complex materials showing outstanding properties which emerge from their particular...
How Cancer-Attractive Are You? Find Out Through This 5-Minute Online Test
How Cancer-Attractive Are You? Find Out Through This 5-Minute Test
With over 3.7 million new cases and 1.9 million deaths every year, cancer represents the...
Scientists Unveil The World’s First Non-Leaching Antimicrobial Medical Gloves
Scientists Unveil The World’s First Antimicrobial Medical Gloves
British researchers now present the world’s first medical gloves designed to prevent the spread of infection. This...
Regenerating from the Inside- Biologists Program Cells to Self-Organize Into 3D-Structures
Biologists Program Cells to Self-Organize Into 3D-Structures
A frequent motif from the self-organization of all multicellular cells is the usage of cell-cell signaling networks to...
Bayer International Fellowship Program 2018 – Life Sciences & Agro Sciences
Bayer Fellowship Program 2018 - Life Sciences & Agro Sciences
Bayer International Fellowship Program - Life Sciences & Agro Sciences 2018 official notification has been...
DST Indo-Russian Joint Research Call for Proposals 2018
DST Indo-Russian Joint Research Call for Proposals 2018
The official notification for the Department of Science & Technology (DST) Indo-Russian Joint Research Call for Proposals 2018 has...
SERB – Core Research Grant (Extra Mural Research Funding Scheme)
SERB - Extra Mural Research Funding Scheme (Life Sciences)
The official notification for the SERB - Extra Mural Research Funding Scheme has been announced. Indian nationals...
Biotecnika Times – Newsletter 04.06.2018 – Jamia Hamdard Fellowship, CSIR RA...
Biotecnika Times - Jamia Hamdard Fellowship, CSIR RA / SRF Online
Online Application Open For CSIR Direct SRF & Research Associate 2018
CSIR Inviting Applications for...
Project Assistant for MSc Biosciences @ Bharathidasan University
Project Assistant for MSc Biosciences @ Bharathidasan University
MSc Microbiology, Biosciences, Life Sciences Project Assistant post at Bharathidasan University. Bharathidasan University Recruitment for Project Post. MSc...
Employing Neurons to Study Impact of Aged Mitochondria on Brain
Employing Neurons to Study Impact of Aged Mitochondria on Brain
Mitochondria are a significant goal for aging and therefore are instrumental in the age-dependent corrosion...
“Darwin’s Beach” Plagued by Plastic Pollution
“Darwin’s Beach” Plagued by Plastic Pollution
The Galapagos Islands were declared a World Heritage Site in 1978 but are currently facing the scourge of plastic...
Experimental Injection Stimulates Brain to Produce New Neurons
Experimental Injection Stimulates Brain to Produce New Neurons
Mammals lack strong regenerative abilities. Missing cells in diminished tissue might potentially be reimbursed by switching local...
Employing Artificial Intelligence for Cancer Detection
Employing Artificial Intelligence for Cancer Detection
Currently, the diagnostic accuracy for melanoma is dependent on the expertise of the treating doctor. Scientists have demonstrated for...
Nested Vesicle Reactors Produce Drugs On-Demand
Nested Vesicle Reactors Produce Drugs On-Demand
Cell-sized vesicles have enormous potential both as miniaturised pL reaction boats and in bottom-up artificial biology as chassis for...